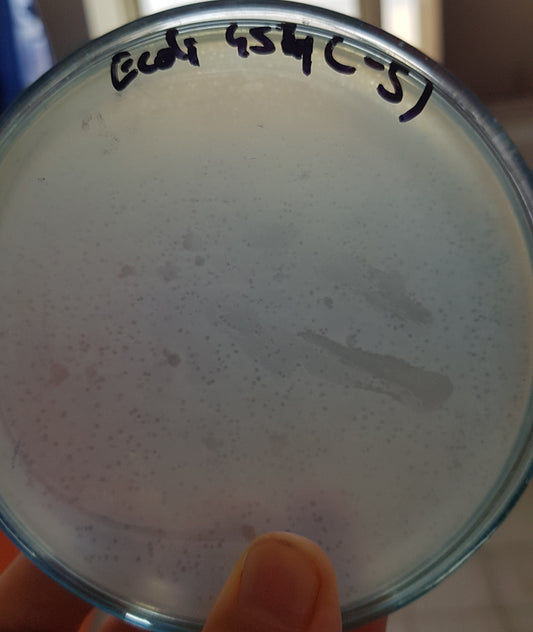
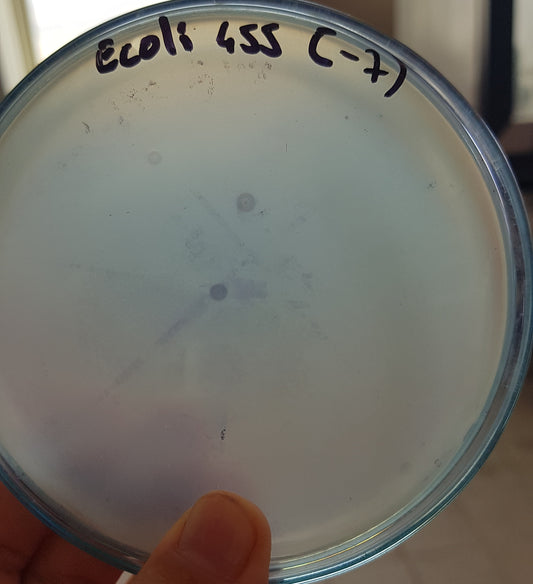
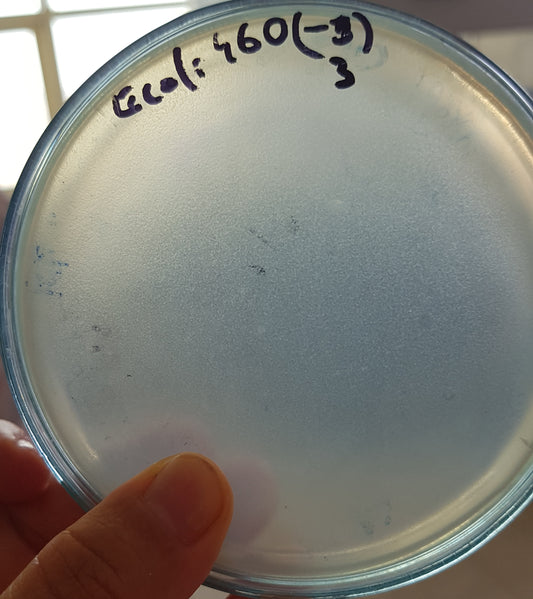
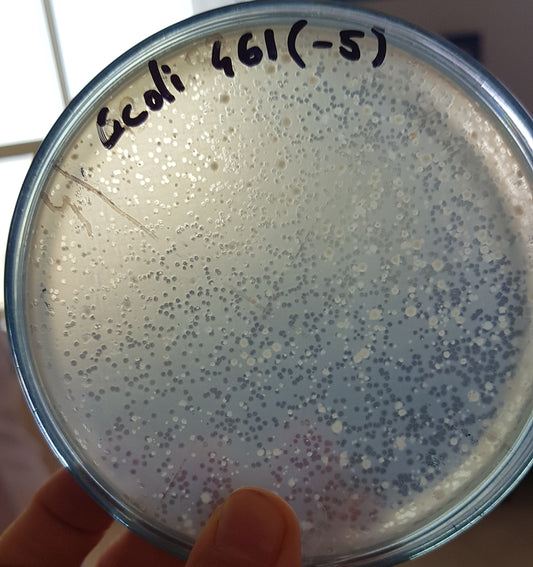
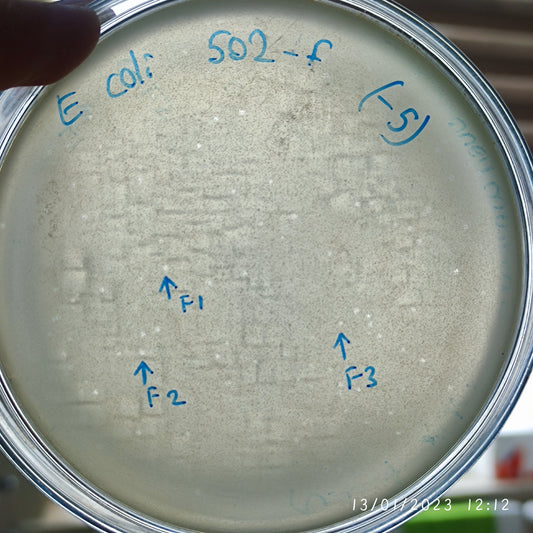
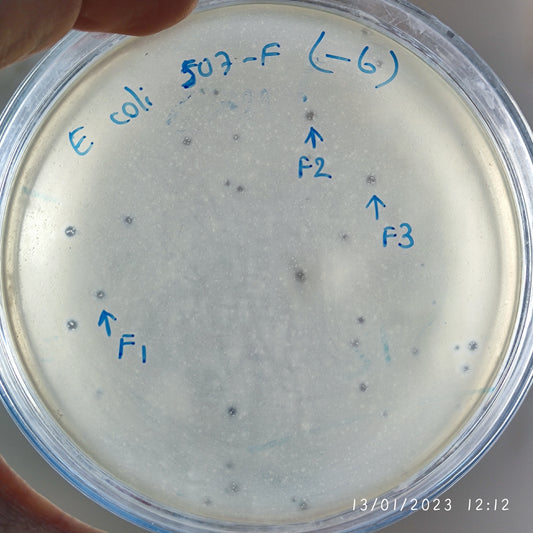
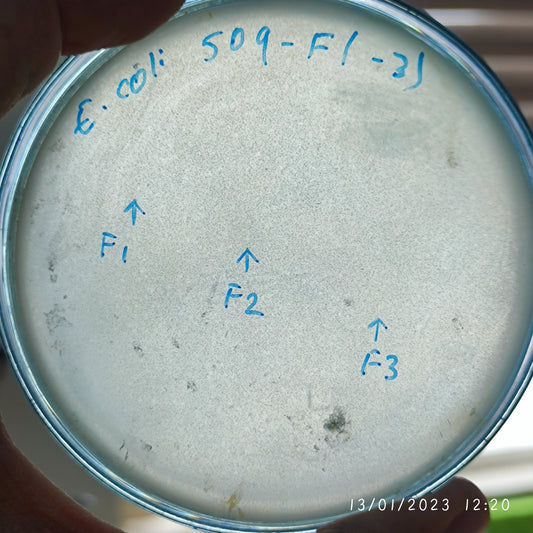
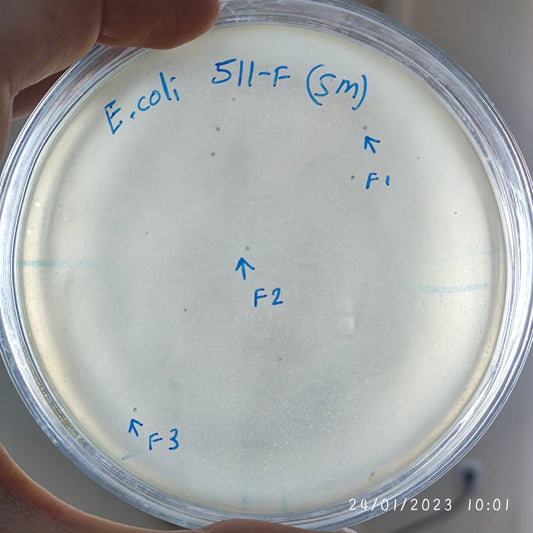
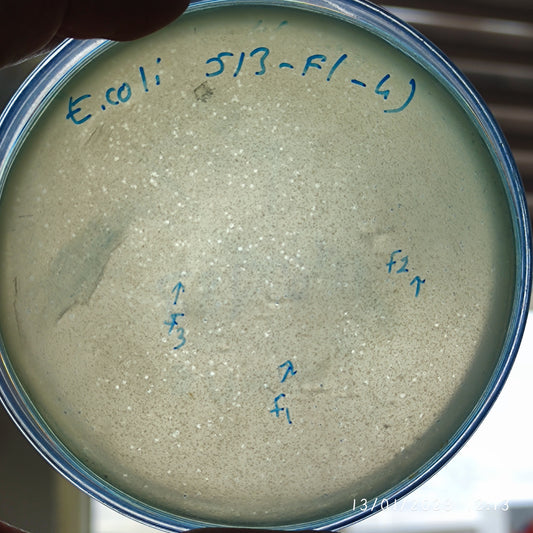
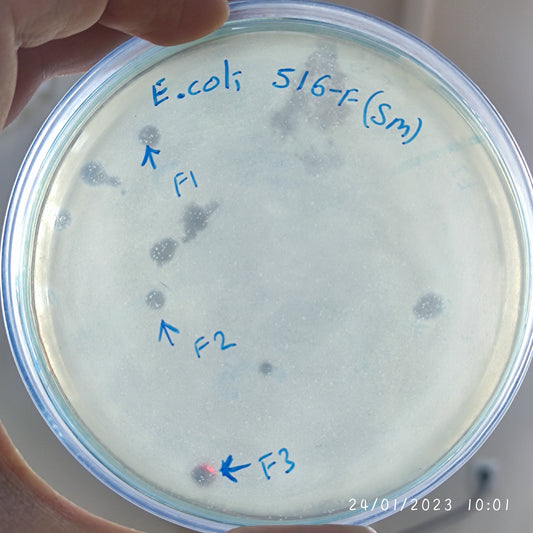

-
Escherichia coli bacteriophage 100454A
Regular price $500.00 USDRegular priceUnit price per -
Escherichia coli bacteriophage 100455A
Regular price $500.00 USDRegular priceUnit price per -
Escherichia coli bacteriophage 100456A
Regular price $500.00 USDRegular priceUnit price per -
Escherichia coli bacteriophage 100460A
Regular price $500.00 USDRegular priceUnit price per -
Escherichia coli bacteriophage 100461A
Regular price $500.00 USDRegular priceUnit price per -
Escherichia coli bacteriophage 100502F
Regular price $500.00 USDRegular priceUnit price per -
Escherichia coli bacteriophage 100503F
Regular price $700.00 USDRegular priceUnit price per -
Escherichia coli bacteriophage 100506F
Regular price $900.00 USDRegular priceUnit price per -
Escherichia coli bacteriophage 100507F
Regular price $500.00 USDRegular priceUnit price per -
Escherichia coli bacteriophage 100509F
Regular price $400.00 USDRegular priceUnit price per -
Escherichia coli bacteriophage 100511F
Regular price $750.00 USDRegular priceUnit price per -
Escherichia coli bacteriophage 100512F
Regular price $750.00 USDRegular priceUnit price per -
Escherichia coli bacteriophage 100513F
Regular price $500.00 USDRegular priceUnit price per -
Escherichia coli bacteriophage 100514F
Regular price $500.00 USDRegular priceUnit price per -
Escherichia coli bacteriophage 100514G
Regular price $500.00 USDRegular priceUnit price per -
Escherichia coli bacteriophage 100516F
Regular price $900.00 USDRegular priceUnit price per